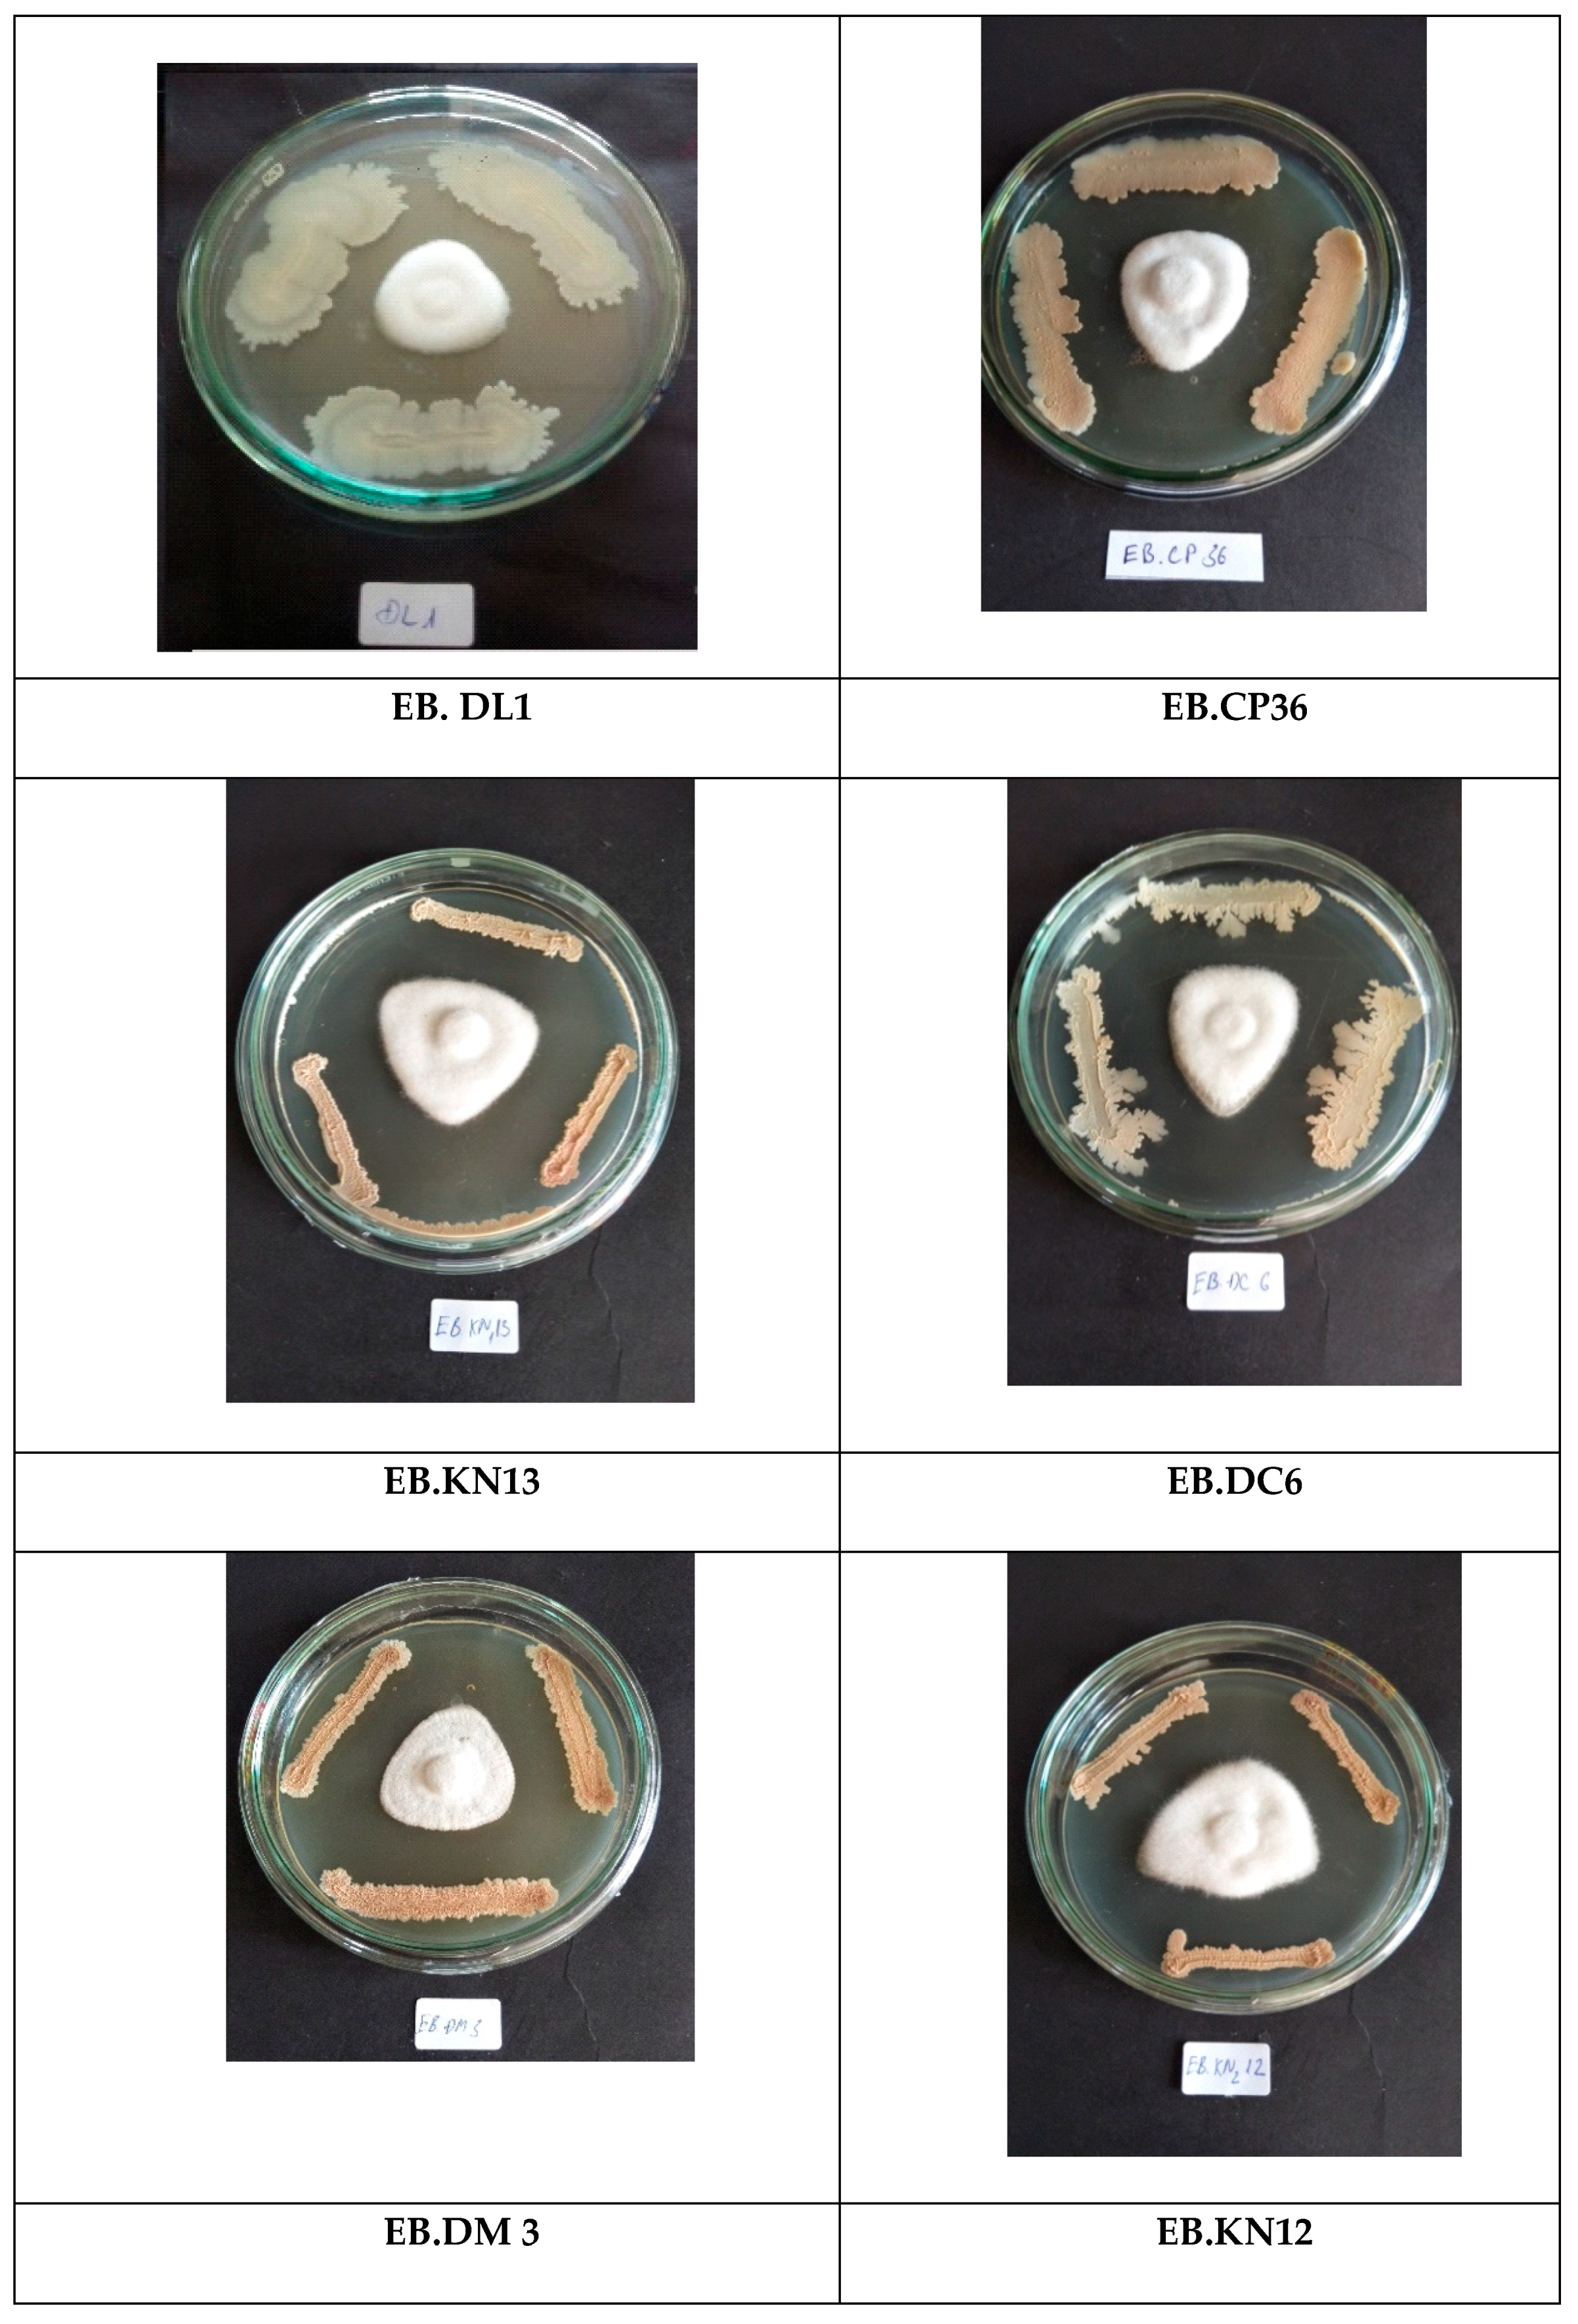
Agronomy 10 00286 g003 Agronomy 10 00286 g003

Phytophthora Antagonism of Endophytic Bacteria Isolated from Roots of Black Pepper (Piper nigrum L.)
Abstract
1. Introduction
2. Materials and Methods
2.1. Method for Sampling
2.2. Isolation of Endophytic Bacteria
2.3. In Vitro Phytophthora Antagonism by the Endophytic Bacteria
2.4. In Vivo Phytophthora Antagonism
2.5. Bioassay in the Greenhouse
2.6. Chitinase Activity of the Endophytic Bacteria
2.7. Protease Activity of the Endophytic Bacteria
2.8. PCR Amplification, Sequencing, and Phylogenetic Analysis of the 16S rRNA Gene
2.9. Data Analysis
3. Results and Discussion
3.1. Isolation and Morphology of Endophytic Bacteria
3.2. Screening Phytophthora Antagonism Activity of the Endophytic Bacteria
3.3. In Vivo Phytophthora Antagonism by the Endophytic Bacteria
3.4. Evaluation of Phytophthora Antagonism in Greenhouse by Endophytic Bacteria
4. Conclusions
Author Contributions
Funding
Conflicts of Interest
References
- Tran, T.P.H.; Wang, S.L.; Nguyen, V.B.; Tran, M.D.; Nguyen, A.D. Study of novel endophytic bacteria for biocontrol of black pepper root-knot nematodes in the Central Highlands of Vietnam. Agronomy 2019, 9, 714. [Google Scholar] [CrossRef]
- Trivedi, P.C.; Malhotra, A. Bacteria in the Management of Plant Parasitic Nematodes, in Bacteria in Agrobiology: Disease Management; Maheshwari, D.K., Ed.; Springer: Berlin, Germany, 2013; pp. 349–377. [Google Scholar]
- Hardoim, P.; Nissinen, R.; Van Elsas, J.D. Ecology of Bacterial endophytes in sustainable agriculture. In Bacteria in Agrobiology: Plant probiotics; Springer: Berlin, Germany, 2012; pp. 97–126. [Google Scholar]
- Bouizgarne, B. Bacteria for plant growth promotion and disease management. In Bacteria in Agrobiology: Disease Management; Maheshwari, D.K., Ed.; Springer: Berlin, Germany, 2013; pp. 15–47. [Google Scholar]
- Ko, W.H.; Tsou, Y.J.; Lin, M.J.; Chern, L.L. Activity and characterization of secondary metabolites produced by a new microorganism for control of plant diseases. New Biotechnol. 2010, 27, 397–402. [Google Scholar] [CrossRef]
- Nguyen, V.B.; Wang, S.L.; Nguyen, T.H.; Nguyen, T.H.; Trinh, T.H.T.; Nong, T.T.; Nguyen, T.U.; Nguyen, V.N.; Nguyen, A.D. Reclamation of rhizobacteria newly isolated from black pepper plant roots as potential biocontrol agents of root-knot nematodes. Res. Chem. Intermed. 2019, 45, 5293–5307. [Google Scholar] [CrossRef]
- Banerjee, D.; Pandey, A.; Jana, M.; Strobel, G. Muscolor albus MOW12 an endophyte of Piper nigrum L. (Piperaceae) collected from North East India produces volatile antimicrobials. Indian J. Microbiol. 2014, 54, 27–32. [Google Scholar] [CrossRef][Green Version]
- Fernando, W.G.D.; Nakkeenran, S.; Zhang, Y. Biosynthesis of antibiotics by PGPR and its relation in biocontrol of plant diseases. In Biocontrol and Biofertilization; Springer: Dordrecht, The Netherlands, 2005; pp. 67–109. [Google Scholar]
- Liang, T.W.; Chen, W.T.; Lin, Z.H.; Kuo, Y.H.; Nguyen, A.D.; Wang, S.L. An amphiprotic novel chitosanase from Bacillus mycoides and its application in the production of chitooligomers with their antioxidant and anti-inflammatory evaluation. Int. J. Mol. Sci. 2016, 17, 1302. [Google Scholar] [CrossRef] [PubMed]
- Wang, C.L.; Su, J.W.; Liang, T.W.; Nguyen, A.D.; Wang, S.L. Production, purification and characterization of a chitosanase from Bacillus cereus. Res. Chem. Intermed. 2014, 40, 2237–2248. [Google Scholar] [CrossRef]
- Dagesta, S.G.; Deepa, C.K.; Pandey, A. Potential plant growth promoting activity of Serratia nematodiphila NII-0928 on black pepper (Piper nigrum L.). World J. Microbiol. Biotechnol. 2011, 27, 259–265. [Google Scholar]
- Nguyen, A.D.; Wang, S.L.; Trinh, T.H.T.; Tran, T.N.; Nguyen, V.B.; Doan, C.T.; Huynh, V.Q.; Vo, T.P.K. Plant growth promotion and fungal antagonism of endophytic bacteria for the sustainable production of black pepper (Piper nigrum L.). Res. Chem. Intermed. 2019, 45, 5325–5339. [Google Scholar] [CrossRef]
- Bhattacharyya, P.N.; Jha, D.K. Plant growth-promoting rhizobacteria (PGPR): Emergence in agriculture. World J. Microbiol. Biotechnol. 2012, 28, 1327–1350. [Google Scholar] [CrossRef]
- Toh, S.C.; Samuel, L.; Awang, A.S.A.H. Screening for antifungal- producing bacteria from Piper nigrum plant against Phytopthora capsici. Int. Food Res. J. 2016, 23, 2616–2622. [Google Scholar]
- Anith, K.N.; Radhakrishnan, N.V.; Manomohandas, T.P. Screening of antagonistic bacteria for biological control of nursery wilt of black pepper (Piper nigrum). Microbiol. Res. 2003, 158, 91–97. [Google Scholar] [CrossRef] [PubMed]
- Trinh, T.H.T.; Wang, S.L.; Nguyen, V.B.; Tran, M.D.; Doan, C.T.; Vo, T.P.K.; Huynh, V.Q.; Nguyen, A.D. A potent antifungal rhizobacteria Bacillus velezensis RB.DS29 isolated from black pepper (Piper nigrum L.). Res. Chem. Intermed. 2019, 45, 5309–5323. [Google Scholar] [CrossRef]
- Aravind, R.; Kumar, A.; Eapen, S.J.; Ramana, K.V. Endophytic bacterial flora in root and stem tissues of black pepper (Piper nigrum L.) genotype: Isolation, identification and evaluation against Phytophthora capsici. Lett. Appl. Microbiol. 2009, 48, 58–64. [Google Scholar] [CrossRef] [PubMed]
- Sheoran, N.; Nadakkakath, A.V.; Munjal, V.; Kundu, A.; Subaharan, K.; Venugopal, V.; Rajamma, S.; Eapen, S.J.; Kumar, A. Genetic analysis of plant endophytic Pseudomonas putida BP25 and chemo-profiling of its antimicrobial volatile organic compounds. Microbiol. Res. 2015, 173, 66–78. [Google Scholar] [CrossRef]
- Partelli, F.L. Nutrient of black pepper: A Brasilian experience. J. Spice Aromat. Crops 2009, 18, 73–83. [Google Scholar]
- Dinesh, R.; Srinivasan, V.; Hamza, S.; Parthasarathy, V.A.; Aipe, K.C. Physico-chemical, biochemical and microbial properties of the rhizospheric soils of tree species used as supports for black pepper cultivation in the humid tropics. Geoderma 2010, 158, 252–258. [Google Scholar] [CrossRef]
- Jasim, B.; Jimtha, C.J.; Jyothis, M.; Radhakrishnan, E.K. Plant growth promoting potential of endophytic bacteria isolated from Piper nigrum. Plant Growth Regul. 2013, 71, 1–11. [Google Scholar] [CrossRef]
- Munjal, V.; Nadakkakath, V.A.; Sheoran, N.; Kundu, A.; Venugopal, V.; Subaharan, K.; Rajamma, S.; Eapen, S.J.; Kumar, A. Genotyping and identification of broad spectrum antimicrobial volatiles in black pepper root endophytic biocontrol agent, Bacillus megaterium BP17. Biol. Control 2016, 92, 66–76. [Google Scholar] [CrossRef]
- Krieg, N.R. Bergey’s Manual of Systematic Bacteriology; Springer: New York, NY, USA, 2010. [Google Scholar]
- Tran, M.D.; Sugimoto, H.; Nguyen, A.D.; Watanabe, T.; Suzuki, K. Identification and characterization of chitinolytic bacteria isolated from a freshwater lake. Biosci. Biotechnol. Biochem. 2018, 82, 343–355. [Google Scholar] [CrossRef]
- Dinu, A.; Kumar, A.; Aravind, R.; Eapen, S.J. Novel in planta assay for selection of antagonistic bacteria against Phytophthora capsici on black pepper (Piper nigrum L). J. Spices Aromat. Crops 2007, 16, 1–7. [Google Scholar]
- Imoto, T.; Yagishita, K. A simple activity measurement of lysozyme. Agric. Biol. Chem. 1971, 35, 1154–1156. [Google Scholar] [CrossRef]
- Anson, M.L. The estimation of pepsin, trypsin, papain and cathepsin with hemoglobin. J. Gen. Physiol. 1938, 22, 79–89. [Google Scholar] [CrossRef] [PubMed]
- Tamura, K.; Stecher, G.; Peterson, D.; Fillipski, A.; Kumar, S. Mega 6: Molecular evoluation genetic analysis version 6.0. Mol. Biol. Evol. 2013, 30, 2725–2729. [Google Scholar] [CrossRef] [PubMed]
- Larkin, M.A.; Blackshields, G.; Brown, N.P. Clustal W and clustal X version 2.0. Bioinformatics 2007, 23, 2947–2958. [Google Scholar] [CrossRef] [PubMed]
- Ulrich, K.; Ulrich, A.; Ewald, D. Diversity of endophytic bacterial communities in poplar grown under field conditions. FEMS Microbiol. Ecol. 2008, 63, 169–180. [Google Scholar] [CrossRef]
- Gu, Q.; Yang, Y.; Yuan, Q.; Shi, G.; Wu, L.; Lou, Z.; Huo, R.; Wu, H.; Borriss, R.; Gao, X. Bacillomycin D produced by Bacillus amyloliquefaciens is involved in the antagonistic interaction with the plant-pathogenic fungus Fusarium graminearum. Appl. Environ. Microbiol. 2017, 83, e01075. [Google Scholar] [CrossRef]
- Fan, B.; Blom, J.; Klenk, H.P.; Borris, R. Bacillus amyloliquefaciens, Bacillus velezensis, and Bacillus siamensis form an operational group B. amyloliquefaciens; within the B. subtilis species complex. Front. Microbiol. 2017, 8, 22. [Google Scholar] [CrossRef]
- Palazzini, J.M.; Dunlap, C.A.; Bowman, M.J.; Chulze, S.N. Bacillus velezensis RC 218 as a biocontrol agent to reduce Fusarium head blight and deoxynivalenol accumulation: Genome sequencing and secondary metabolite cluster profiles. Microbiol. Res. 2016, 192, 30–36. [Google Scholar] [CrossRef]
- Krober, M.M.; Verwaaijen, B.; Wibberg, D.; Winkler, A.; Pühler, A.; Schlüter, A. Comparative transcriptome analysis of the biocontrol strain Bacillus amyloliquefaciens FZB42 as response to biofilm formation analyzed by RNA sequencing. J. Biotechnol. 2016, 231, 212–223. [Google Scholar] [CrossRef]
- Cai, X.C.; Liu, C.H.; Wang, B.T.; Xue, Y.R. Genomic and metabolic traits endow Bacillus velezensis CC09 with a potential biocontrol agent in control of wheat powdery mildew disease. Microbiol. Res. 2017, 196, 89–94. [Google Scholar] [CrossRef]
- Cheng, X.; Ji, X.; Li, J.; Qi, W.; Qiao, K. Characterization of antagonistic Bacillus methylotrophicus isolated from rhizosphere and its biocontrol effects on maize stalk rot. Phytopathology 2019, 109, 571–581. [Google Scholar] [CrossRef] [PubMed]

| No. | Isolates | Phytophthora Mycelium Growth Inhibition (%) |
|---|---|---|
| 1 | EB.CP17 | 60.83 ± 0.42 e |
| 2 | EB.CP24 | 54.58 ± 0.42 ijk |
| 3 | EB.CP26 | 56.25 ± 0.72 i |
| 4 | EB.CP27 | 52.50 ± 0.72 klm |
| 5 | EB.CP31 | 58.83 ± 0.65 fgh |
| 6 | EB.CP35 | 55.00 ± 0.72 ijk |
| 7 | EB.CP36 | 63.42 ± 0.80 d |
| 8 | EB.CP37 | 50.00 ± 0.72 op |
| 9 | EB.CS05 | 60.42 ± 0.55 ef |
| 10 | EB.CS08 | 52.29 ± 0.55 mno |
| 11 | EB.CS20 | 51.25 ± 0.36 nop |
| 12 | EB.DC2 | 56.25 ± 0.36 i |
| 13 | EB.DC3 | 58.96 ± 0.21 fgh |
| 14 | EB.DC6 | 65.84 ± 0.75 c |
| 15 | EB.DS02 | 51.88 ± 0.36 no |
| 16 | EB.DS03 | 52.33 ± 0.40 mno |
| 17 | EB.DS07 | 55.00 ± 0.36 ijk |
| 18 | EB.DL1 | 68.34 ± 0.91 b |
| 19 | EB.DL2 | 60.00 ± 0.36 efg |
| 20 | EB.DM3 | 71.17 ± 1.09 a |
| 21 | EB.DM4 | 50.83 ± 0.55 op |
| 22 | EB.DM22 | 52.50 ± 0.36 klm |
| 23 | EB.DM23 | 55.83 ± 0.55 i |
| 24 | EB.DM26 | 53.96 ± 0.26 jkl |
| 25 | EB.DM34 | 55.96 ± 0.46 i |
| 26 | EB.DM31 | 58.96 ± 0.21 fgh |
| 27 | EB.DM41 | 50.83 ± 0.55 op |
| 28 | EB.KN1.4 | 53.96 ± 0.26 jkl |
| 29 | EB.KN1.5 | 55.96 ± 0.46 i |
| 30 | EB.KN1.7 | 58.42 ± 0.49 gh |
| 31 | EB.KN1.13 | 63.63 ± 0.38 d |
| 32 | EB.KN1.8 | 51.46 ± 0.18 nop |
| 33 | EB.KN2.01 | 51.08 ± 0.23 nop |
| 34 | EB.KN2.03 | 58.17 ± 0.47 h |
| 35 | EB.KN2.04 | 58.42 ± 0.49 gh |
| 36 | EB.KN2.05 | 55.21 ± 0.25 ijk |
| 37 | EB.KN2.12 | 66.46 ± 1.10 c |
| 38 | EB.KN2.14 | 55.13 ± 0.31 ijk |
| 39 | EB.CK01 | 60.96 ± 0.18 e |
| 40 | EB.CK07 | 51.13 ± 0.38 nop |
| 41 | EB.CK09 | 50.13 ± 0.83 p |
| 42 | EB.CK15 | 59.08 ± 0.18 fgh |
| 43 | EB.CK17 | 55.29 ± 0.18 ij |
| 44 | EB.CK22 | 51.79 ± 0.08 no |
| 45 | EB.EH05 | 58.13 ± 0.36 h |
| 46 | EB.EH09 | 61.17 ± 0.29 e |
| 47 | EB.EH11 | 52.46 ± 0.40 klm |
| 48 | Control | 0 |
| No | Isolates | Scientific name | DDBJ/EMBL/GenBank Code |
|---|---|---|---|
| 1 | EB.CP36 | Bacillus siamensis | LC506615 |
| 2 | EB.DC6 | Bacillus amyloliquefaciens | LC506616 |
| 3 | EB.DL1 | Bacillus amyloliquefaciens | LC506617 |
| 4 | EB.DM3 | Bacillus amyloliquefaciens | LC506618 |
| 5 | EB.KN12 | Bacillus velezensis | LC506619 |
| 6 | EB.KN13 | Bacillus methylotrophicus | LC506620 |
| Isolates | Chitinase * Activity (U/mL) | Protease Activity ** (U/mL) | Phytophthora Mycelium Growth Inhibition *** (%) | Lesion Inhibition **** (%) |
|---|---|---|---|---|
| EB.CP36 | 0.507 ± 0.009 a | 7.372 ± 0.60 a | 62.71 ± 0.62 d | 90.49 ± 2.26 b |
| EB.DC6 | 0.125 ± 0.001 d | 7.880 ± 0.03 a | 65.84 ± 1.30 bc | 12.00 ± 1.57 c |
| EB.DL1 | 0.343 ± 0.020 c | 4.218 ± 0.26 b | 68.34 ± 1.57 b | 93.57 ± 1.04 ab |
| EB.DM3 | 0.406 ± 0.010 b | 1.335 ± 0.55 c | 71.17 ± 1.88 a | 96.29 ± 0.24 a |
| EB.KN12 | 0.154 ± 0.000 d | 1.491 + 0.01 c | 66.46 ± 1.91 b | 96.38 ± 1.63 a |
| EB.KN13 | 0.502 ± 0.080 a | 3.965 ± 0.08 b | 63.63 ± 0.66 cd | 94.02 ± 1.97 ab |
| Treatments | Leaf Number/Plant | Plant Height (cm) | Diameter of Shoot (mm) | Length of Root (cm) | Fresh Biomass (g) | Rate of Root Disease (%) | Fatal Rate of Plant (%) |
|---|---|---|---|---|---|---|---|
| EB.CP36 | 9.50 ± 0.39 ab | 60.73 ± 2.69 a | 3.34 ± 0.10 ab | 16.09 ± 0.55 a | 11.26 ± 0.21 b | 8.45 ± 1.55 d | 15.55 ± 3.85 bc |
| EB.DC6 | 9.26 ± 0.24 b | 53.40 ± 1.18 c | 3.45 ± 0.14 ab | 13.15 ± 0.63 d | 11.01 ± 0.12 b | 24.03 ± 0.19 a | 28.89 ± 7.69 a |
| EB.DL1 | 9.71 ± 0.28 ab | 46.68 ± 2.29 d | 3.48 ± 0.04 a | 14.33 ± 0.19 c | 9.40 ± 0.12 c | 17.33 ± 0.60 b | 20.00 ± 0.00 abc |
| EB.DM3 | 9.84 ± 0.33 ab | 55.00 ± 1.22 bc | 3.47 ± 0.16 a | 13.00 ± 0.40 d | 9.54 ± 0.23 c | 14.71 ± 2.77 c | 17.78 ± 7.70 bc |
| EB.KN12 | 10.28 ± 0.57 a | 58.04 ± 2.00 ab | 3.41 ± 0.13 ab | 15.37 ± 0.66 b | 11.25 ± 0.40 b | 11.21 ± 1.65 cd | 11.11 ± 3.84 c |
| EB.KN13 | 10.37 ± 0.24 a | 59.49 ± 2.19 a | 3.38 ± 0.26 ab | 15.70 ± 0.38 ab | 11.97 ± 0.07 a | 14.21 ± 1.15 c | 13.33 ± 6.66 c |
| Control 1 | 9.73 ± 0.19 ab | 48.01 ± 1.46 d | 3.17 ± 0.14 c | 12.93 ± 0.33 d | 8.71 ± 0.26 d | 9.38 ± 2.41 d | 8.89 ± 3.84 c |
| Control 2 | 6.90 ± 0.9 c | 43.47 ± 0.77 e | 3.17 ± 0.17 c | 12.07 ± 0.22 e | 7.98 ± 0.13 e | 24.81 ± 1.75 a | 24.44 ± 7.69 ab |
© 2020 by the authors. Licensee MDPI, Basel, Switzerland. This article is an open access article distributed under the terms and conditions of the Creative Commons Attribution (CC BY) license (http://creativecommons.org/licenses/by/4.0/).
Share and Cite
Ngo, V.A.; Wang, S.-L.; Nguyen, V.B.; Doan, C.T.; Tran, T.N.; Tran, D.M.; Tran, T.D.; Nguyen, A.D. Phytophthora Antagonism of Endophytic Bacteria Isolated from Roots of Black Pepper (Piper nigrum L.). Agronomy 2020, 10, 286. https://doi.org/10.3390/agronomy10020286
Ngo VA, Wang S-L, Nguyen VB, Doan CT, Tran TN, Tran DM, Tran TD, Nguyen AD. Phytophthora Antagonism of Endophytic Bacteria Isolated from Roots of Black Pepper (Piper nigrum L.). Agronomy. 2020; 10(2):286. https://doi.org/10.3390/agronomy10020286
Chicago/Turabian StyleNgo, Van Anh, San-Lang Wang, Van Bon Nguyen, Chien Thang Doan, Thi Ngoc Tran, Dinh Minh Tran, Trung Dzung Tran, and Anh Dzung Nguyen. 2020. "Phytophthora Antagonism of Endophytic Bacteria Isolated from Roots of Black Pepper (Piper nigrum L.)" Agronomy 10, no. 2: 286. https://doi.org/10.3390/agronomy10020286
APA StyleNgo, V. A., Wang, S.-L., Nguyen, V. B., Doan, C. T., Tran, T. N., Tran, D. M., Tran, T. D., & Nguyen, A. D. (2020). Phytophthora Antagonism of Endophytic Bacteria Isolated from Roots of Black Pepper (Piper nigrum L.). Agronomy, 10(2), 286. https://doi.org/10.3390/agronomy10020286

